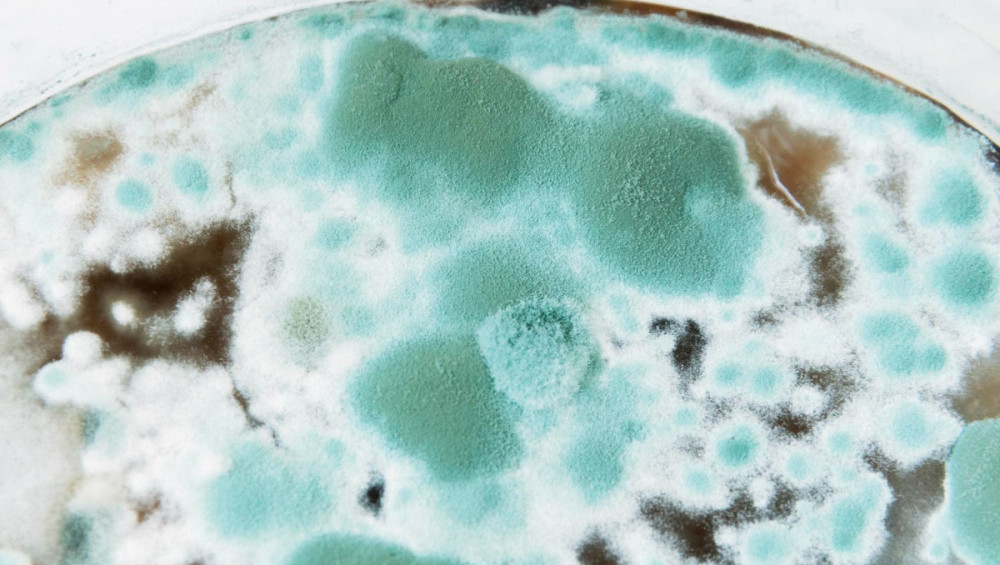
Цікаві факти про цвіль

Завдяки цвілі було здійснено безліч наукових відкриттів, значення яких складно переоцінити. Вона цінна і в медицині, і в харчовій промисловості, причому ще в давнину деякі народи були обізнані про деякі її корисні властивості, хоч і досить поверхово. Утім, усе залежить від виду і від того, як її застосовувати – шкоди від цвілі може бути не менше, ніж користі.
- Суворо кажучи, цвіль є особливим видом грибів.
- Зараження паперу пліснявою в архівах і сховищах є основною причиною пошкоджень документів і загрозою для їхнього збереження.
- Останні дослідження японських учених довели, що цвіль має зачатки інтелекту.
- На Землі цвіль з'явилася задовго до предків людей, ще близько 200 мільйонів років тому.
- Найотруйнішою є цвіль жовтого кольору. Вражаючи харчові продукти, вона виробляє найсильнішу отруту.
- Цвіль може бути причиною підвищеної стомлюваності, головного болю, дерматологічних, легеневих і навіть онкологічних захворювань.
- З організму цвіль практично не виводиться.
- Деякі її види можуть руйнувати штукатурку, цеглу і навіть бетон.
- На Кавказі знаходиться печера, де було виявлено флуоресцентну цвіль. Причому флюоресценція настільки сильна, що з відстані в метр можна легко розрізнити риси обличчя людини, яка стоїть поруч.
- Після проникнення в гробницю фараона Тутанхамона 24 листопада 1922 року від невідомої хвороби померла більша частина команди англійських археологів, які брали участь у пошуках мумії. І лише 1999 року німецький мікробіолог Готтард Крамер досліджував понад 40 муміфікованих тіл і виявив, що кожне з них вкрите шаром дуже небезпечної плісняви, концентрація якої і призвела до смерті тих, хто ввійшов до гробниці.
- Саме з цвілі було вперше видобуто пеніцилін, що дало змогу вченим винайти антибіотики.
- Цвіль зовсім не боїться радіації. Наприклад, під саркофагом 4-го енергоблоку Чорнобильської АЕС знаходиться величезна кількість цвілі. У місцях посиленого радіаційного фону вона найбільш густа.
- Спори цвілевих грибів літали в космос на обшивці космічного корабля. Час показав, що в безповітряному просторі вона не тільки вижила, а й обзавелася сильним імунітетом.
- Крім агресивної та небезпечної цвілі існує й та, яку можна вживати в їжу. У Франції її використовують для приготування вин і називають «благородною».
- За допомогою спеціально вирощеної блакитної плісняви роблять мармурові та блакитні сири.
- Особливий і дуже дорогий делікатес – ковбаса з пліснявою, яку роблять в Італії. Ковбаску витримують у підвальних приміщеннях близько місяця, після чого вона вкривається світло-зеленою пліснявою і вирушає на спеціальну обробку, і вже через три місяці нею можна поласувати.











Вміст розділів, що стосуються азартних ігор або будь-якої букмекерської діяльності, призначений виключно для відвідувачів віком від 21 року. Усі матеріали, пов’язані з темою азартних ігор, у тому числі з онлайн-казино чи ставками на результати спортивних подій, мають виключно інформаційно-пізнавальний та оглядовий характер. Сайт не є організатором, посередником чи партнером жодного онлайн-казино або букмекерської компанії, не розміщує рекламних матеріалів і не спонукає до участі в азартних іграх. Усі згадки про сторонні ресурси та посилання на них подані виключно з метою ілюстрації та підвищення інформативності матеріалів.